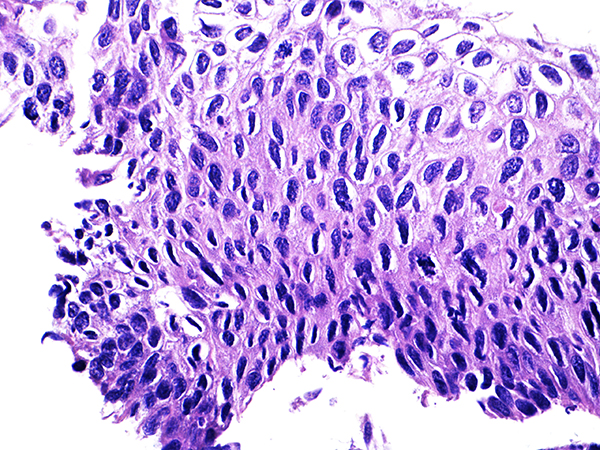

Histopathology Cases
|
||
|
Case 1
Soft Bx CIN 2 10x - Low Power
|
 Case 1
Area 1 - Soft Bx CIN 2 40x - High Power |
 Case 1
Area 2 - Soft Bx CIN 2 40x - High Power |
 Case 2
Soft Bx CIN 2 10x - Low Power |
 Case 2
Soft Bx CIN 2
40x - High Power
|
|
 Case 3
Soft Bx CIN 2-3 10x - Low Power
|
 Case 3
Soft Bx CIN 3
10x - Low Power |
 Case 3
Soft Bx CIN 3
40x - High Power |
 Case 4
Soft Bx CIN 3
10x - Low Power |
Case 4
Soft Bx CIN 3
40x - High Power |
|
 Case 5
Soft Bx CIN 1
10x - Low Power |
 Case 5
Soft Bx CIN 1
40x - High Power |
|
 Case 6
Soft ECC CIN 1
40x - High Power |

Case 7
Soft ECC CIN 2
40x - High Power |
 Case 8
Soft ECC CIN 2-3
10x - Low Power |
 Case 9
Soft ECC CIN 3
40x - High Power |
||
 HGSIL Soft Bx
Low Power |
 HGSIL Soft ECC Low Power |
|
